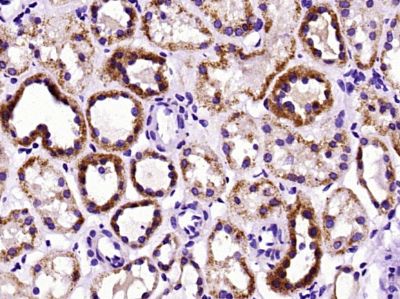
硒蛋白O抗体

硒蛋白O抗体
目录号:bs-19630R
计量单位:PC
商品规格:100ul
分享商品:
无规格
这是用户近期浏览商品预览.
只要用户查看过一个商品这个片断就会显示.
只要用户查看过一个商品这个片断就会显示.